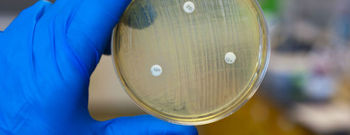

الصليب الأحمر الألماني: عدد المتطوعين لمواجهة إيبولا لا يزال قليلا
برلين 22 تشرين أول/أكتوبر 2014 (د ب أ)- ذكر مدير الصليب الأحمر الألماني أن عدد المتطوعين للمشاركة في مواجهة انتشار وباء إيبولا في غرب أفريقيا لا يزال قليلا.
وأضاف رودولف زايترز لصحيفة "دي فيلت" الألمانية الصادرة اليوم الأربعاء أن عدد المتطوعين الذين قاموا بتسجيل أنفسهم لعملية التطوع يبلغ نحو 480 متطوعا، لم يكن مناسبا منهم سوى 196 متطوعا فقط.
وأشار زايترز: "هذا العدد لا يكفي على المدى البعيد لتشغيل المستشفيات على مدار شهور قادمة"؛ لأنه من المقرر تغيير طاقم العمل كل أربعة أسابيع.
تجدر الإشارة إلى أن الصليب الأحمر الألماني يعتزم البدء بشكل فوري في تشغيل مركز علاجي في مدينة كينيما بسيراليون.
ومن المقرر أن يتولى الصليب الأحمر مسؤولية إدارة مركز علاجي أيضا بالعاصمة الليبيرية مونروفيا بدعم من الجيش الألماني.
وأضاف زايترز صباح اليوم لإذاعة ألمانيا: "يتمثل العنصر الأهم لتحقيق إمكانية تشغيل هذه المراكز العلاجية في توفير طاقم طبي".